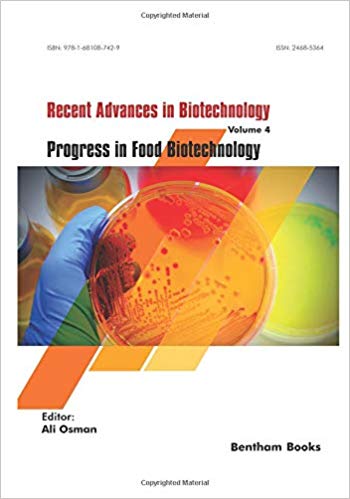
Progress in Food Biotechnology (Recent Advances in Biotechnology)-Original PDF

Plant- and Marine- Based Phytochemicals for Human Health: Attributes, Potential, and Use (Innovations in Plant Science for Better Health)-Original PDF
Plant- and Marine- Based Phytochemicals for Human Health: Attributes, Potential, and Use (Innovations in Plant Science for Better Health)-Original PDF Amazon Price $40 By…